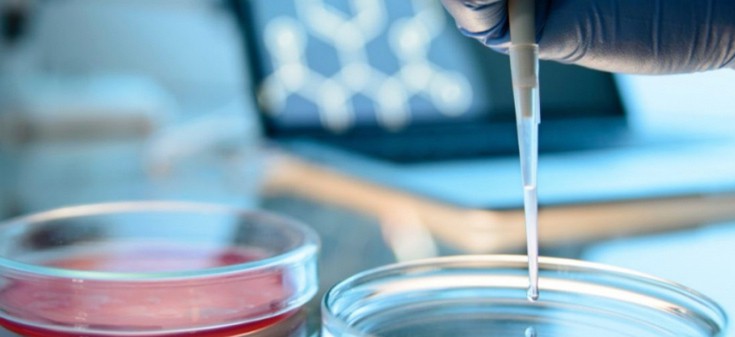
woma4 woma4

Ο καρκίνος του μαστού αποτελεί το 41% περίπου των επιβιούντων γυναικών με καρκίνο. Με την πρόοδο, που έχει σημειωθεί την τελευταία δεκαετία στην διάγνωση και την θεραπεία, αυξάνονται συνεχώς οι γυναίκες, στις οποίες ο καρκίνος διαγιγνώσκεται σε πρώιμα στάδια, με αποτέλεσμα μακρά επιβίωση ή ίαση. Πως είναι όμως η ζωή μετά τις αρχικές θεραπείες; Πως πρέπει να γίνεται η παρακολούθηση; Τι μπορεί να κάνει μία ασθενής για να μειώσει τον κίνδυνο υποτροπής; 
Εξετάσεις παρακολούθησης

Αλλαγές του τρόπου ζωής